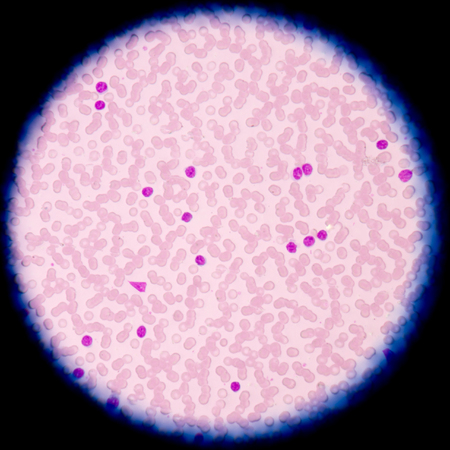

Что такое лимфома Беркитта
Лимфома Беркитта является злокачественным поражением лимфатической системы, отвечающей за иммунитет. Лимфома Беркитта - одна из разновидностей неходжкинских лимфом. Данное заболевание отличается высокой агрессивностью. Встречается лимфома Беркитта чаще всего у детей в возрасте 3-7 лет, особенно проживающих в Центральной Африке и Океании. Однако в последние годы участились случаи заболевания в США и Европе.
Причины и предрасполагающие факторы
Причины, по которым возникает лимфома Беркетта, достоверно неизвестны. Патологический процесс начинается в результате бесконтрольного деления В-лимфоцитов - клеток иммунной системы. Избыток клеток накапливается в костном мозге, лимфатических узлах, спинномозговой жидкости, что приводит к нарушениям работы всего организма.
Следует отметить, что основным фактором риска является проживание в регионах, где высокая заболеваемость малярией, в частности в Африке. Кроме того, к предрасполагающим к лимфоме Беркитта факторам можно отнести следующие:
- ВИЧ, СПИД
- вирус Эпштейна-Барр
- хроническая малярия
- сниженный иммунитет
Симптоматика лимфомы Беркитта
Лимфома может поражать почти любой орган. Лимфома Беркитта чаще всего локализуется в месте перехода тонкого кишечника в толстый. Опухоль также может располагаться в желудке, поджелудочной железе, яичках, почках, надпочечниках, яичниках. Как правило, изначально опухоль формируется в лимфатических узлах, а потом уже распространяется на внутренние органы.
При лимфоме Беркитта возможны следующие симптомы:
- повышенная утомляемость
- потеря аппетита и массы тела
- повышенная температура тела
- повышенная потливость, особенно в ночное время
- при поражении челюстей - деформации лица и носовой перегородки вследствие образования опухоли
- при поражении почек и мочеточников - интоксикация, отечность
- при поражении кишечника - боли и вздутие живота, кровь в кале
Диагностика лимфомы Беркитта
Для выявления лимфомы Беркитта сегодня применяются следующие диагностические методы:
- лабораторные исследования крови позволяют определить изменения клеточного состава крови, ПЦР-диагностика дает возможность выявить вирус Эпштейна-Барр, ВИЧ
- рентгенография дает возможность выявить наличие опухолевого процесса на разных участках организма
- компьютерная томография помогает определить особенности локализации опухоли
- позитронно-эмиссионная томография с компьютерной томографией позволяет еще более детально изучить опухоль и ее расположение
- анализ спинномозговой жидкости применяется для оценки распространенности злокачественного процесса, а также контроля результатов лечения
- биопсия используется для уточнения диагноза и установления стадии заболевания
Лечение лимфомы Беркитта в Израиле
Лечение лимфомы Беркитта назначается в зависимости от стадии заболевания, распространенности и локализации злокачественного процесса, общего состояния пациента и наличия у него сопутствующих заболеваний. Лечение лимфомы тем эффективнее, чем раньше выявлено заболевание.
Сегодня израильские врачи проводят лечение лимфомы Беркитта при помощи таких современных методов, как:
- химиотерапия
- биологическая терапия
- лучевая терапия
- трансплантация стволовых клеток
Химиотерапия - это основной метод лечения лимфомы Беркитта. Комбинации современных цитостатических препаратов назначаются индивидуально и могут вводится либо внутривенно, либо непосредственно в спинномозговую жидкость.
Биологическая терапия - метод, основанный на применении моноклональных антител, которые повышают чувствительность злокачественных клеток к действию иммунной системы больного. Таким образом, иммунная защита организма возрастает и опухоль уничтожается естественным путем.
Лучевая терапия при лимфоме Беркитта используется для подавления роста опухоли на пораженных участках. Современная аппаратура, применяемая в израильских клиниках, позволяет минимизировать облучение здоровых тканей.
Трансплантация стволовых клеток применяется на поздних стадиях лимфомы Беркитта. Данный метод позволяет восстановить кроветворную систему после курса агрессивной химиотерапии.
Подробная http://www.rak-krovi.com/






